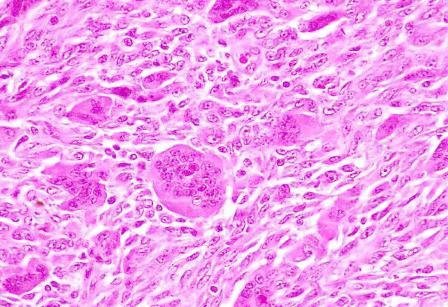

Con el objetivo de reducir la morbidad-mortalidad de los tumores epiteliales malignos reduciendo el número de exploraciones y por consiguiente el coste. El Dr. Alberto del Valle Manteca expone un estudio que contempla realizar un diagnóstico precoz de los diferentes tipos de tumores epiteliales, apoyándose en un registro tumoral que valora la cronología o intervalo de tiempo transcurrido entre diferentes estadios tumorales, valorando la creación de un Diagnostico Cronológico Tumoral
Este diagnóstico cronológico nos permitirá realizar con mejor criterio exploraciones sucesivas para obtener diagnósticos tumorales, por técnicas de imagen fundamentalmente, estableciendo la realización de un Screening Predictivo. Diagnóstico Precoz Predictivo Dirigido a una población diana de alto riesgo, indicada por datos epidemiológicos y por patología crónica conocida, en vez de screening periódico
Este estudio inicialmente persigue ponderar la importancia que tiene la prevención de los factores de riesgo en la reducción de la morbilidad de los canceres epiteliales. Sin embargo la reducción de la mortalidad es el objetivo principal de este trabajo, y para lograrlo es necesario resaltar la importancia del diagnóstico epidemiológico, referente a el censo de una población en un del año concreto.
Disponer del censo y de los datos de morbilidad y mortalidad de una población y de un año, nos facilita una guía orientativa para que el año siguiente y así sucesivamente, se pueda valorar:
• Si se mantiene una constante en el Número de canceres de cada tipo tumoral.
• Si el Rango de cada tipo de cáncer, con el número concreto de canceres en cada década, guarda una concordancia anualmente con el censo.
• Que es necesario identificar un Diagnostico Cronológico de cada tipo tumoral para realizar un Diagnostico Precoz Predictivo con una periodicidad definida, aumentando la eficacia de la prueba.
• Screening dirigido a la población diana de alto riesgo en cada tipo de cáncer epitelial.
• La población diana de cada tipo tumoral que está constituida por aquellas personas que presentan patología conocida de la víscera u órgano de estudio. Víscera que tipifica el diagnóstico del cáncer epitelial.
• Finalmente y como conclusión fundamental establecer un Diagnostico Precoz Predictivo, que reduzca la clasificación TNM de los canceres a Estadios Iniciales.
Se adjunta PDF del trabajo íntegro.